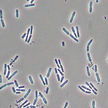

top of page
labfrusco


Fitopatología
En nuestro Laboratorio de Fitopatología contamos con los siguientes servicios:

PARÁMETROS
Hongos
Bacterias
Nemátodos
Hongos | Bacterias
Hongos | Nemátodos
Bacterias | Nemátodos
Hongos | Bacterias | Nemátodos
IEB (Índice de Estabilidad Biológica)
Micorrizas
Plagas
Please reload
PRODUCTOS BIOLÓGICOS
Tipificación
Conteo Total
Conteo de Viabilidad
Pureza Microbiológica
Determinación de especies

ELISA (VIRUS)
Kit por muestra *
Please reload
bottom of page